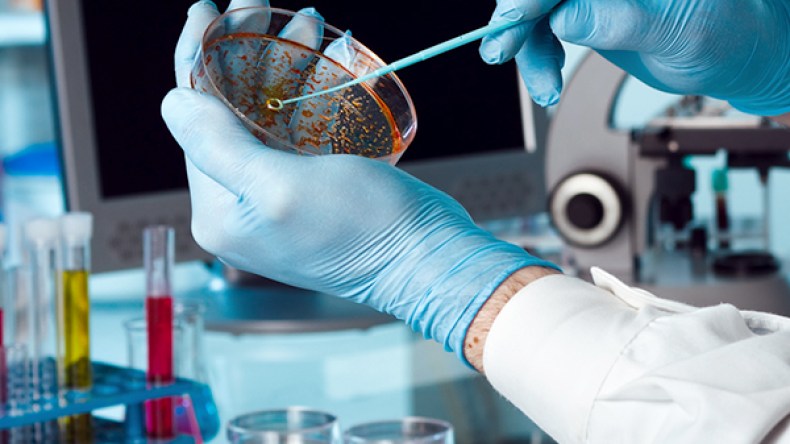
باحث جزائري ينجح في إيجاد دواء للسيدا وأمراض مستعصية أخرى

باحث جزائري ينجح في إيجاد دواء للسيدا وأمراض مستعصية أخرى
كشف، الباحث في الطب فؤاد خروبي لـ “الشروق”، أنّه توصل إلى نتائج مبهرة لعلاج عدد من الأمراض المستعصية والفتاكة، على غرار التوصل إلى علاج داء السيدا ومرض الصدفية، وكذا الجروح المستعصية وكذا مختلف أنواع الالتهابات، الباحث كشف أنه توصل إلى هذه النتائج بعد عمليات البحث المستمر دون انقطاع طيلة 27 سنة من الاختبار والتجريب.
الباحث البالغ من العمر 44 سنة القاطن بمدينة وهران، والحاصل على شهادة مهندس في الإعلام الآلي، كشف لـ “الشروق”، أنّ بداية مشواره مع البحث في الطب بدأت وعمره لم يتجاوز 17 سنة، حيث كان يعاني خلالها من حساسية مفرطة، جعلته يتوقف لمدة عن الدراسة الثانوية بثانوية العقيد لطفي وسط وهران، والتي كان فيها من أنجب التلاميذ قصد العلاج بعدما حبسه المرض عن مغادرة منزله وهناك بدأ مشواره في البحث العلمي من داخل منزله العائلي، حيث حول مطبخ بيته العائلي إلى مختبر علمي لإيجاد علاج للحساسية التي عانى منها، وهو ما جعله يتوصل لعلاج نفسه بعدما عجز الأطباء عن علاجه، وهي البداية التي مهدت للباحث الطريق لمواصلة مشوار البحث العلمي وكلّه ثقة في إيجاد أدوية من شأنها القضاء على عدد من الأمراض، هذا وأكد الباحث فؤاد خروبي، أنّ نتائج بحثه أوصلته إلى إيجاد علاج للقضاء على داء السيدا، مؤكّدا أنّه قام بتجريبه على أحد المرضى المصابين حديثا بالفيروس فأعطى الدواء الذي يتكون من مرهم للعلاج الخارجي ومحلول للشرب، نتائج جد إيجابية حيث شفي المريض بنسبة مائة بالمائة، بعد إعادة إجراء التحاليل الطبية، معتبرا أن هذا الدواء الذي توصل إليه يمكن أن يعالج المصاب بالسيدا حتى في مراحل متقدمة، مؤكدا أن هذا الدواء المتوصل إليه يحتاج إلى تجريب من طرف الوزارة الوصية من خلال تبنيها للمشروع العلاجي الذي يحمله الباحث ودعمه حتى يحقق الأهداف المرجوة منه، هذه النتائج المبهرة التي توصل إليها الباحث لم تكن فقط لعلاج داء السيدا، بل توصل أيضا إلى إيجاد دواء وهو عبارة عن مرهم لعلاج مختلف الجروح المؤقتة منها والدائمة، وكذا إيجاد مرهم يقضي على مرض الصدفية و”الروماتيزم والإكزيما” والجروح التي يعاني منها الصابون بداء السكري، وهي الجروح التي تؤدي في أحيان كثيرة إلى بتر أرجل المريض، معتبرا أن ما توصل إليه في نتائج بحثه سيقضي على هذه الجروح ويعالجها تماما من دون اللجوء إلى بتر أعضاء المريض، هذا وكشف الباحث أن ما توصل إليه جاء بعد تجارب عديدة وتحويل المادة الفعالة والمعروفة لدى المختصين في الطب إلى مواد أخرى والتي أطلق عليها تسمية ـ تسيير المادة الفعلة ـ، وعن التركيبة التي يتكون منها هذا الدواء تحفظ الباحث عن ذكر محتواها مشيرا فقط إلى أنها تخلو من أي مواد كيميائية ومتكونة من زيوت طبيعية مستخلصة أساسا من نباتات، مؤكدا أنها غير مكلفة ومتوفرة بكثرة لدينا.
كل هذه النتائج المتوصل إليها جعلت من الباحث يطالب وزير الصحة عبد المالك بوضياف، باستقباله لعرض ما توصل إليه من نتائج علمية ربما ستكون قفزة في مجال الطب لإنقاذ الكثير من المرضى الذين يعانون في المستشفيات، منتقدا الحواجز والعوائق التي تلقاها من طرف مسؤولين في قطاع الصحة ببلادنا على اعتبار أنّه باحث حر في مجال الطب وغير منخرط ضمن المجالس العلمية التي تقوم بالبحوث الطبية، وهو ما جعل أبحاثه يحتفظ بها لنفسه، ويقوم بعلاج بعض الحالات في بيته الخاص، مطالبا لقاء وزير الصحة لعرض المشروع عليه وتطويره.















